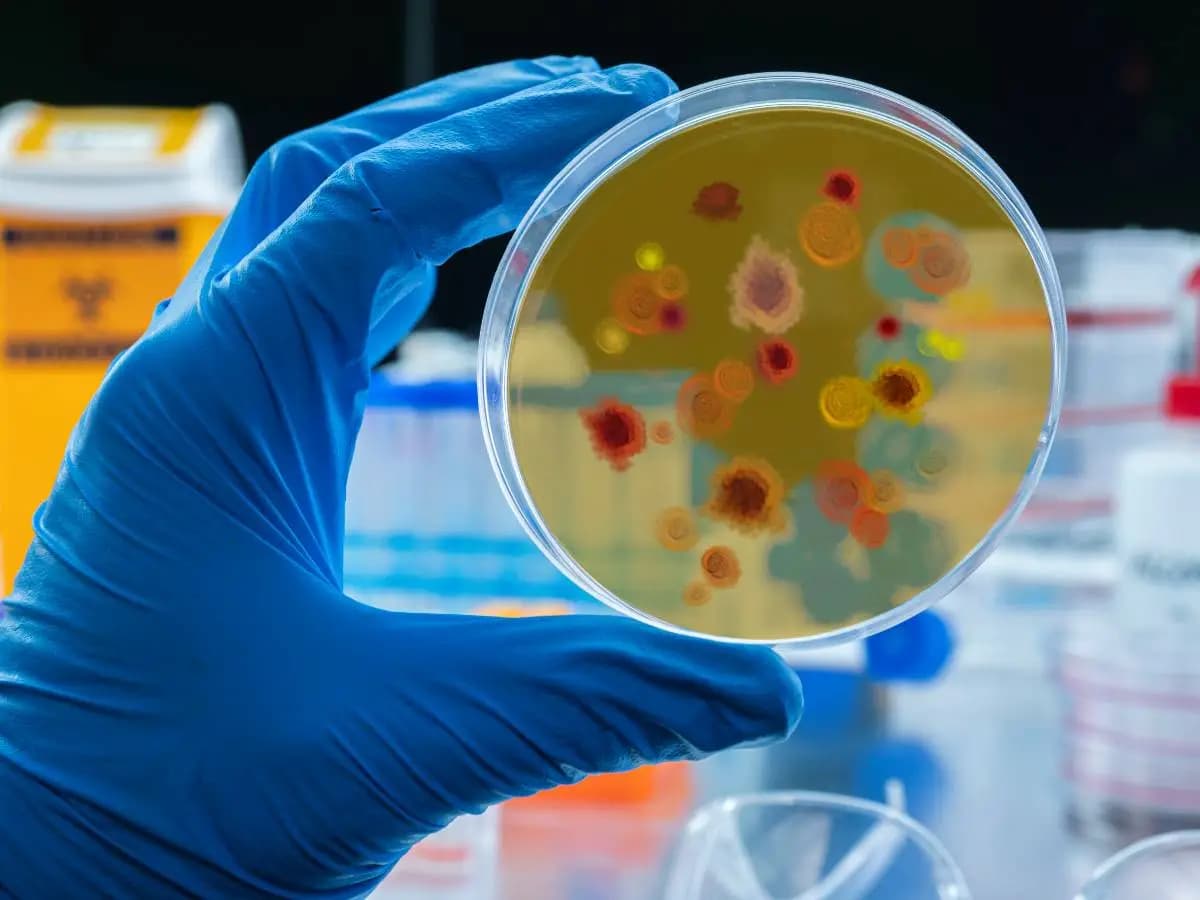
Resistenza agli antibiotici, sempre più batteri la sviluppano

Resistenza agli antibiotici, sempre più batteri la sviluppano
Gli antibiotici sono la nostra miglior arma contro i batteri ma la resistenza dei piccoli organismi ai medicinali sta aumentando. A lanciare l’allarme ci ha pensato un report dell’Organizzazione Mondiale della Sanità che ha raccolto dati da tutto il mondo. La situazione non è uniforme ma la paura è che i decessi connessi alle infezioni possano aumentare drasticamente nei prossimi anni.
Batteri: quanti sono resistenti agli antibiotici?
Il Global antibiotic resistance surveillance report 2025 dell’OMS è stato chiaro: i batteri che sviluppano resistenza agli antibiotici sono in continuo aumento. A livello mondiale ormai un patogeno su sei non risponde ai medicinali e la situazione è drasticamente peggiorata negli ultimi anni. Tra il 2018 e il 2023 i microorganismi con tali caratteristiche sono cresciuti del 40%, con un incremento annuo compreso tra il 5 e il 15%.
Ciò ha implicazioni importanti per la salute pubblica. Nel 2021 a livello globale le morti causate da infezioni sono state 7.7 milioni. 4.71 di queste erano in qualche modo legate a batteri resistenti agli antibiotici e 1.14 milioni di decessi sono stati direttamente causati da questi ultimi. Al ritmo attuale le vittime di tali patogeni potrebbero arrivare a essere il 70% in più entro il 2050.
Quali batteri sviluppano resistenza agli antibiotici?
La resistenza agli antibiotici non si sviluppa in modo omogeneo nel mondo. Il report dell’OMS ha coinvolto 104 Paesi ed è apparso evidente che la sorte peggiore tocca alle realtà in via di sviluppo. Nel Sud Est Asiatico un patogeno su tre non risponde alle terapie e lo stesso vale per l’area orientale del Mediterraneo. In Africa il valore è di un microrganismo su cinque.
Tra i batteri maggiormente resistenti agli antibiotici gli scienziati hanno individuato Escherichia coli e Klebsiella pneumoniae, capaci di provocare sepsi. Oltre il 40% dei primi e il 55% dei secondi sono apparsi capaci di sopravvivere alle cefalosporine, antibiotici di terza generazione che rappresentano la prima scelta contro tali infezioni. In Africa questo tasso di resistenza ha toccato quota 70%.
Batteri e resistenza agli antibiotici: cosa fare
Il nuovo studio dell’OMS mostra che contrastare la resistenza agli antibiotici dei batteri rappresenta una priorità. Al di là dei medicinali e dei patogeni già citati, infatti, a preoccupare sono anche altre situazioni. Carbapenemi e fluorochinoloni sono tra gli altri antibiotici che stanno perdendo efficacia e infezioni da salmonella e Acinetobacter si fanno più pericolose. Persino alcuni trattamenti contro la Gonorrea appaiono meno risolutivi.
La causa della problematica è da ricercare soprattutto nell’uso massiccio di antibiotici e nella somministrazione di terapie non specifiche. La velocità di evoluzione dei microrganismi sta per altro surclassando quella del progresso del settore farmaceutico. Talvolta i medicinali necessari risultano inoltre troppo costosi e molti pazienti, soprattutto nelle aree in via di sviluppo, non vi hanno accesso.
Arrestare lo sviluppo di resistenza agli antibiotici da parte dei batteri non è possibile ma limitare i danni sì. L’OMS chiede dunque un attento monitoraggio dei dati ed evidenzia che quanto riportato riflette probabilmente una sottovalutazione del problema. Gli esperti sottolineano anche che mettere a punto nuovi medicinali non è più sufficiente perché è necessario concentrare gli sforzi sullo sviluppo di farmaci ad hoc.
Le informazioni contenute in questo articolo sono da intendersi a puro scopo informativo e divulgativo e non devono essere intese in alcun modo come diagnosi, prognosi o terapie da sostituirsi a quelle farmacologiche eventualmente in atto. In nessun caso sostituiscono la consulenza medica specialistica. L’autore ed il sito declinano ogni responsabilità rispetto ad eventuali reazioni indesiderate.






